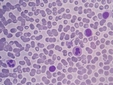
İdrarda Epitel Tedavisi

İdrarda köpüklenmenin nedenleri nelerdir?
İdrarda köpüklenme, çeşitli sağlık durumlarının belirtisi olabilen bir durumdur. Dehidratasyon, proteinüri, pH dengesizlikleri, idrar yolu enfeksiyonları ve hipertansiyon gibi faktörler köpük oluşumunu etkileyebilir. Sürekli köpüklenme yaşanıyorsa, uzman bir doktora danışmak önemlidir.
İdrarda Köpüklenmenin Nedenleri Nelerdir?İdrarda köpüklenme, genellikle idrarın yüzeyinde meydana gelen köpük veya kabarcıkların oluşumu olarak tanımlanabilir. Bu durum, bazı durumlarda normal kabul edilirken, bazen de sağlık sorunlarının bir belirtisi olabilir. Bu makalede, idrarda köpüklenmenin olası nedenlerini detaylı bir şekilde ele alacağız. 1. DehidratasyonDehidratasyon, vücudun yeterli miktarda sıvı almadığı durumlarda ortaya çıkar. Vücut su kaybı yaşadığında, idrar yoğunlaşır ve bu da köpük oluşumuna neden olabilir. İdrar, normalden daha yoğun hale geldiğinde, bu durum yüzey gerilimini artırarak köpüklenmeye sebep olabilir.
2. ProteinüriProteinüri, idrarda normalden fazla protein bulunması durumudur. Sağlıklı bireylerin idrarında genellikle çok az protein bulunur. Ancak böbreklerin hasar görmesi veya çeşitli hastalıklar sonucunda idrarda aşırı protein birikimi gerçekleşebilir. Bu durum, köpüklenmeye neden olabilen bir diğer önemli faktördür.
3. İdrar pH Düzensizlikleriİdrarın pH değeri, asidik veya bazik özellikler taşıyabilir. İdrar pH'ındaki dengesizlikler, köpüklenme olayını etkileyebilir. Örneğin, idrarın aşırı asidik veya bazik olması, yüzey gerilimini değiştirerek köpük oluşumuna yol açabilir.
4. İdrar Yolu Enfeksiyonlarıİdrar yolu enfeksiyonları (İYE), idrarın kalitesini etkileyen ve köpüklenmeye neden olabilen bir diğer önemli etmendir. Enfeksiyonlar, idrarın kimyasal bileşimini değiştirebilir ve bu da köpük oluşumuna yol açabilir.
5. Hipertansiyon ve Kalp HastalıklarıYüksek tansiyon ve kalp hastalıkları, böbrek fonksiyonlarını olumsuz yönde etkileyebilir. Bu durum, idrarda protein kaybına ve dolayısıyla köpüklenmeye neden olabilir.
Sonuçİdrarda köpüklenme, çoğu zaman zararsız bir durum olarak görülebilir. Ancak, sürekli bir köpüklenme durumu yaşıyorsanız, bu bir sağlık sorununun belirtisi olabilir. Bu nedenle, böyle bir durumla karşılaştığınızda bir sağlık uzmanına danışmanız önemlidir. İdrarda köpüklenmenin nedenleri çeşitlilik gösterebilir ve doğru bir teşhis için tıbbi değerlendirme gerekmektedir. Ekstra Bilgiler |











.webp)














.webp)




.webp)








.webp)

İdrarda köpüklenme yaşadığınızda, bunun nedenleri hakkında bilgi sahibi olmak önemli. Dehidratasyon, vücudun yeterli sıvı almadığı durumlarda ortaya çıkabiliyor. Yetersiz sıvı alımının yanı sıra sıcak hava koşulları ve fiziksel aktivite sonrasında sıvı kaybı da bu durumu etkileyebilir mi? Diğer yandan, idrarda aşırı protein bulunması da köpüklenmeye sebep olabiliyor. Böbrek hastalıkları veya yüksek tansiyon gibi sağlık sorunlarının da etkisi olabilir mi? Ayrıca, idrar pH dengesizlikleri veya idrar yolu enfeksiyonları da bu durumu tetikleyebilir. Bu konuda aklınızdaki tüm soruları sağlık uzmanınıza danışarak netleştirmek en doğrusu değil mi? Unutmayın, sağlık her zaman öncelikli olmalı.
Sayın Sulhi Bey, idrarda köpüklenme konusunda verdiğiniz bilgiler doğru ve önemli. Bu durumun yaygın nedenlerini şöyle özetleyebilirim:
Dehidratasyon: Yetersiz sıvı alımı, sıcak hava ve fiziksel aktivite sonrası sıvı kaybı idrarın konsantre hale gelmesine ve köpüklenmeye yol açabilir.
Proteinüri: İdrarda aşırı protein bulunması, böbrek hastalıkları veya yüksek tansiyon gibi durumlarda görülebilir ve köpüklenmeye neden olabilir.
Diğer Faktörler: İdrar pH dengesizlikleri, idrar yolu enfeksiyonları veya hızlı idrar çıkışı da köpük oluşumunu tetikleyebilir.
Kesinlikle haklısınız, bu tür belirtilerde bir sağlık uzmanına danışmak en doğru yaklaşımdır. İdrar tahlili ve gerekli tetkiklerle altta yatan neden netleştirilebilir. Sağlığınızı ön planda tutmanız önemli.